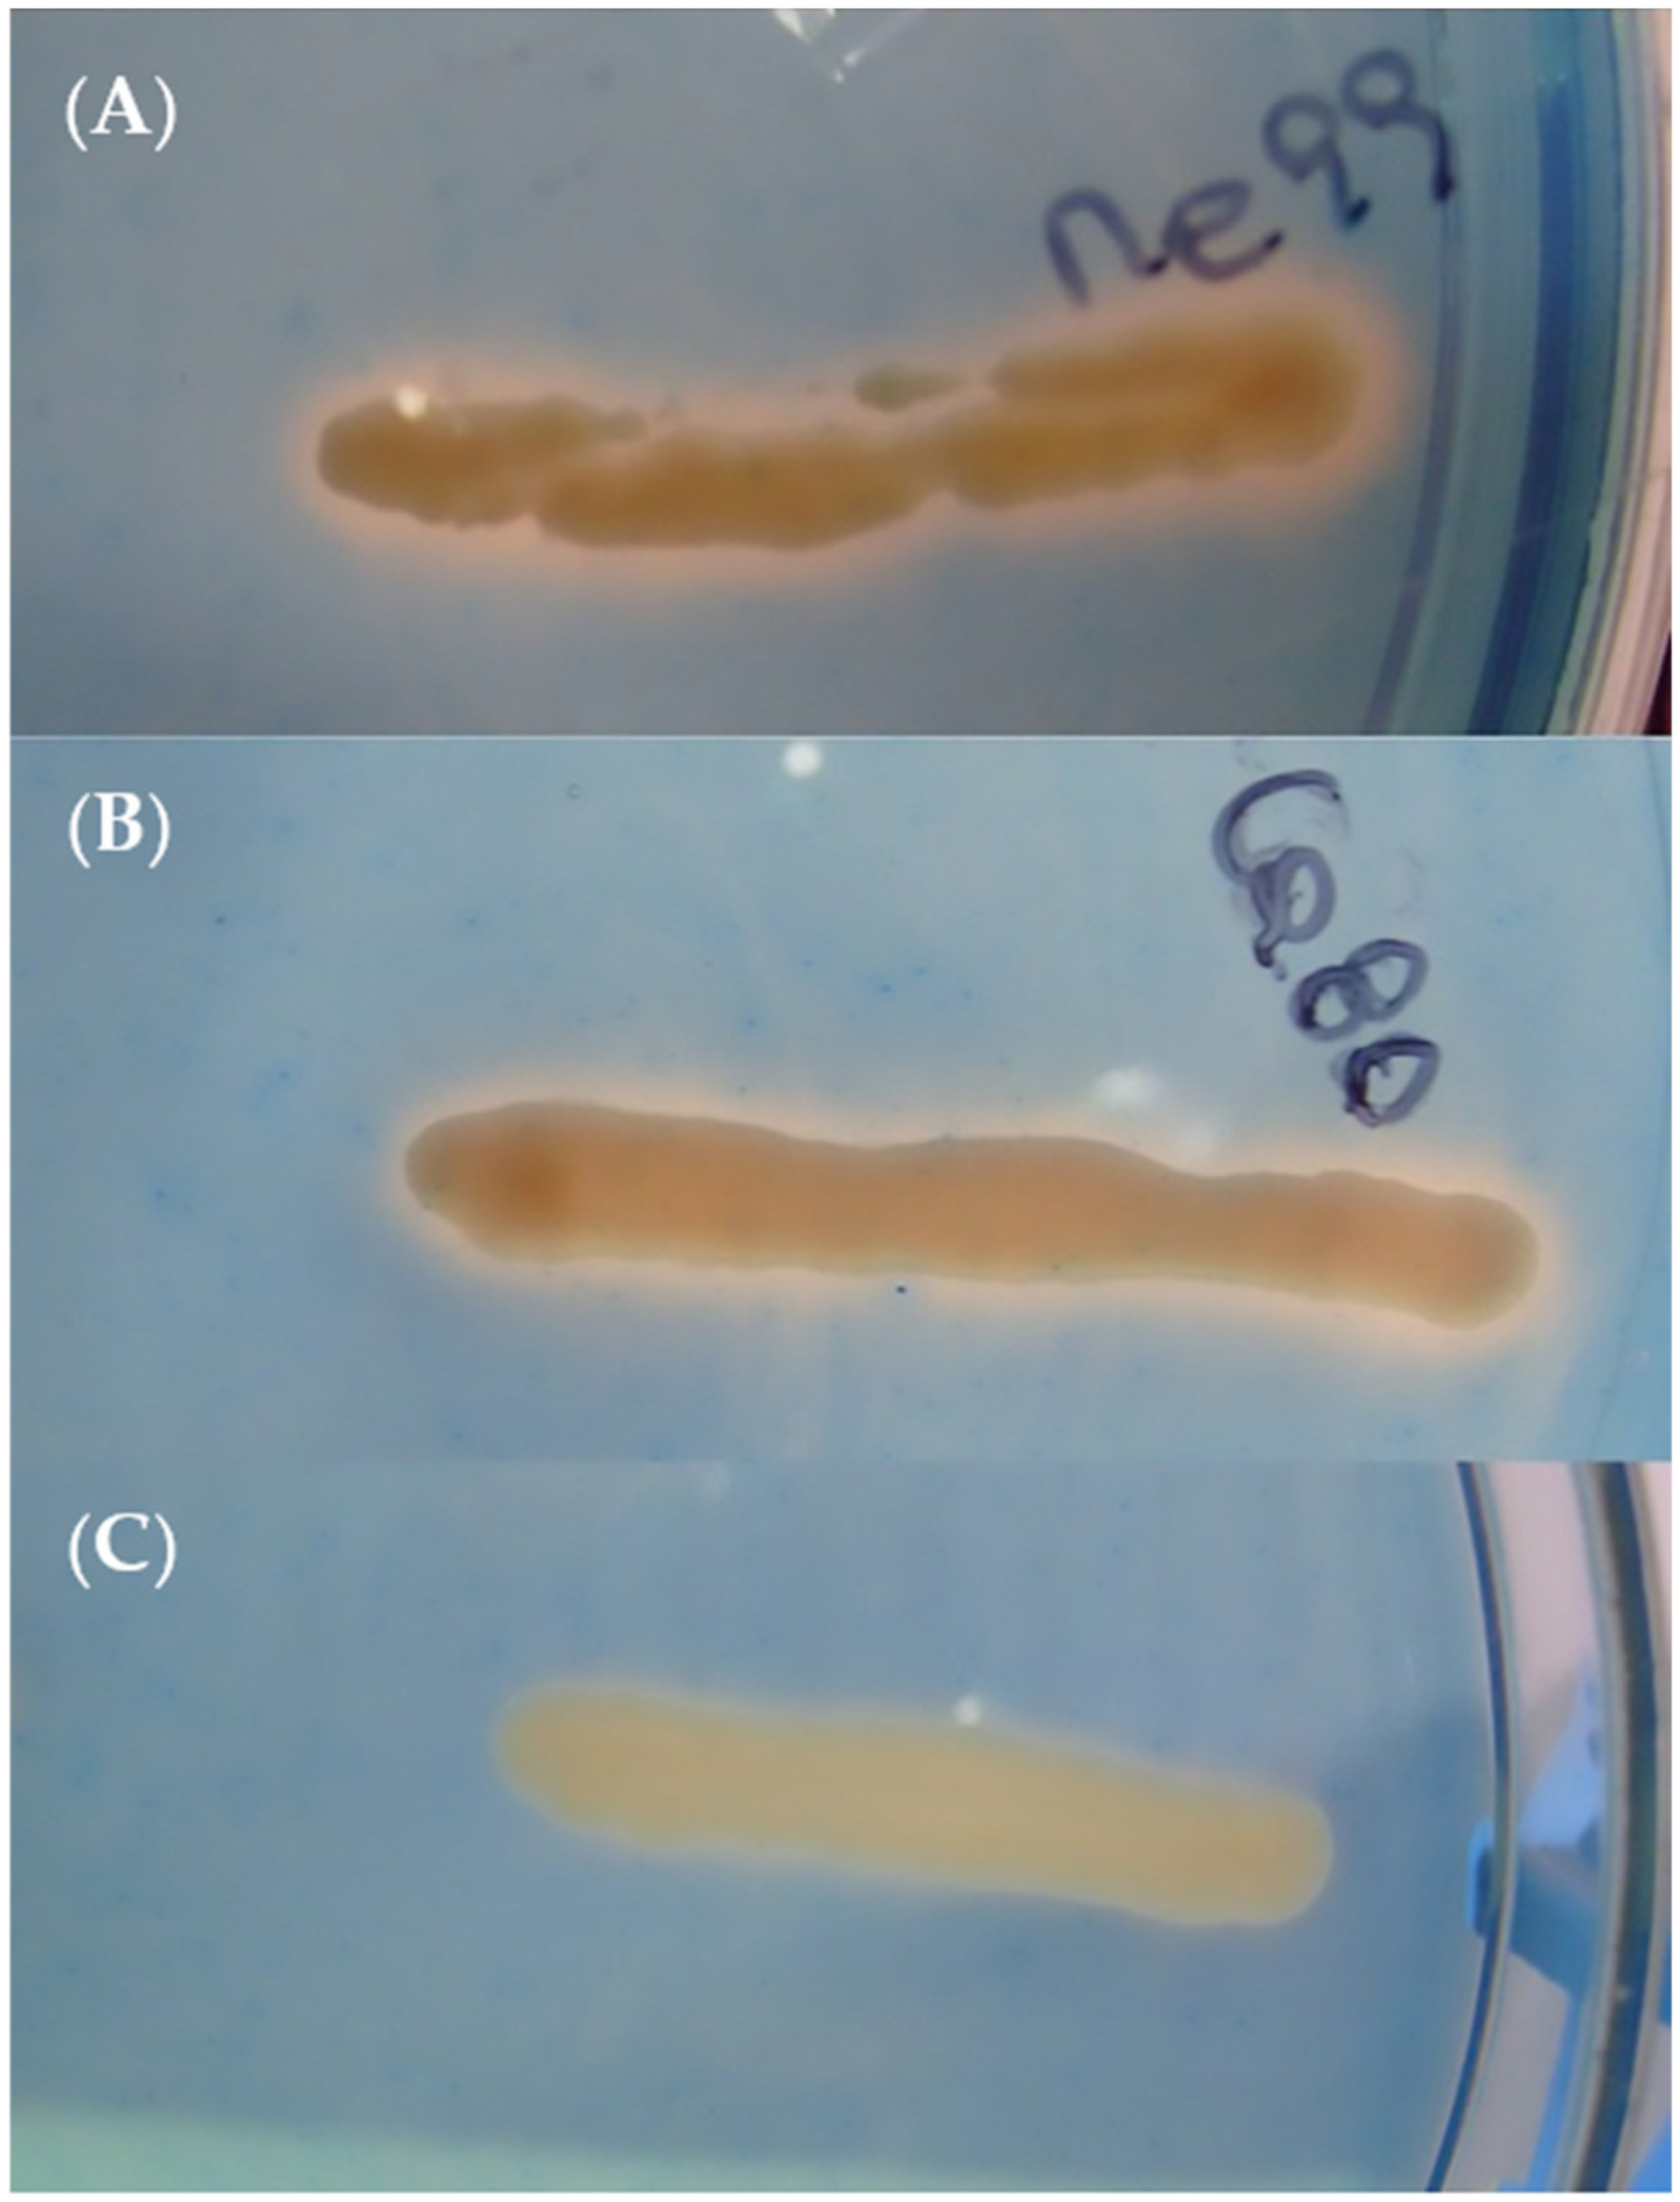

Indigenous Yeasts for the Biocontrol of Botrytis cinerea on Table Grapes in Chile
Abstract
1. Introduction
2. Materials and Methods
2.1. Fruit
2.2. Pathogen
2.3. Antagonists
2.4. Selecting Yeasts with Antagonistic Activity against Botrytis cinerea
2.4.1. Inhibition of Mycelial Growth of Botrytis cinerea
2.4.2. Inhibition of Gray Mold Rot on Table Grape Berries
2.5. Identifying Yeasts with Biocontrol Potential against Botrytis cinerea
2.6. Effect of Yeast on Botrytis cinerea Spore Germination
2.7. Effect of Yeast Concentration on Biocontrol Efficacy of Botrytis cinerea In Vivo
2.8. Population Dynamics of Yeasts in the Wounds
2.9. Evaluating Oxidative Stress Tolerance
2.10. Determination of Different Modes of Action for Selected Yeast Strains
2.10.1. Antifungal Activity
2.10.2. Secretion of β-1,3-Glucanase and Chitinase Activity
2.10.3. Siderophore Production
2.10.4. Production of Biofilm
2.11. Data Analysis
3. Results
3.1. Obtaining Antagonistic Yeasts
3.2. Selecting Yeasts with Antagonistic Activity against Botrytis cinerea
3.2.1. Inhibiting Mycelial Growth of Botrytis cinerea
3.2.2. Inhibition of Gray Mold Rot on Table Grapes
3.3. Identifying Yeasts with Biocontrol Potential against Botrytis cinerea
3.4. Effect of Yeast on Botrytis cinerea Spore Germination
3.5. Effect of Yeast Concentration on Biocontrol Efficacy of Botrytis cinerea in Fruit
3.6. Population Dynamics of Yeasts in the Wounds
3.7. Evaluating Oxidative Stress Tolerance
3.8. Determination of Yeast Modes of Action
3.8.1. Antifungal Activity
3.8.2. Secretion of β-1,3-Glucanase and Chitinase Activity
3.8.3. Siderophore Production
3.8.4. Production of Biofilm
4. Discussion
Author Contributions
Funding
Institutional Review Board Statement
Informed Consent Statement
Data Availability Statement
Acknowledgments
Conflicts of Interest
References
- Esterio, M.; Osorio-Navarro, C.; Azócar, M.; Copier, C.; Rubilar, M.; Pizarro, L.; Auger, J. Reduced fitness cost and increased aggressiveness in fenhexamid-resistant Botrytis cinerea field isolates from Chile. Phytopathol. Mediterr. 2021, 60, 69–77. [Google Scholar] [CrossRef]
- Agrios, G.N. Plant Pathology, 5th ed.; Elsevier Academic Press: Burlington, MA, USA, 2005; ISBN 978-0-08-047378-9. [Google Scholar]
- Holz, G.; Coertze, S.; Williamson, B. The Ecology of Botrytis on Plant Surfaces. In Botrytis: Biology, Pathology and Control; Elad, Y., Williamson, B., Tudzynski, P., Delen, N., Eds.; Springer: Dordrecht, The Netherlands, 2007; pp. 9–27. ISBN 978-1-4020-2624-9. [Google Scholar]
- Latorre, B.A.; Elfar, K.; Ferrada, E.E. Gray mold caused by Botrytis cinerea limits grape production in Chile. Cienc. Investig. Agrar. 2015, 42, 305–330. [Google Scholar] [CrossRef]
- Latorre, B.; Lillo, C.; Rioja, M. Effect of timing on the efficacy of fungicide treatments applied against Botrytis cinerea of gapevine. Cienc. Investig. Agrar. 2001, 28, 61–66. [Google Scholar] [CrossRef]
- Latorre, B.A. Dicarboximide-Resistant Isolates of Botrytis cinérea from Table Grape in Chile: Survey and Characterization. Plant Dis. 1994, 78, 990. [Google Scholar] [CrossRef]
- Esterio, M.; Auger, J.; Ramos, C.; García, H. First Report of Fenhexamid Resistant Isolates of Botrytis cinerea on Grapevine in Chile. Plant Dis. 2007, 91, 768. [Google Scholar] [CrossRef]
- Esterio, M.; Muñoz, G.; Ramos, C.; Cofré, G.; Estévez, R.; Salinas, A.; Auger, J. Characterization of Botrytis cinerea Isolates Present in Thompson Seedless Table Grapes in the Central Valley of Chile. Plant Dis. 2011, 95, 683–690. [Google Scholar] [CrossRef]
- Piqueras, C.M.; Herrera, D.; Latorre, B.A. First Report of High Boscalid Resistance in Botrytis cinerea Associated with the H272L Mutation in Grapevine in Chile. Plant Dis. 2014, 98, 1441. [Google Scholar] [CrossRef]
- Esterio, M.; Araneda, M.J.; Román, A.; Pizarro, L.; Copier, C.; Auger, J. First Report of Boscalid Resistant Botrytis cinerea Isolates Carrying the Mutations H272R, H272Y, P225L, and P225H from Table Grape in Chile. Plant Dis. 2015, 99, 891. [Google Scholar] [CrossRef]
- Zhang, H.; Godana, E.A.; Sui, Y.; Yang, Q.; Zhang, X.; Zhao, L. Biological control as an alternative to synthetic fungicides for the management of grey and blue mould diseases of table grapes: A review. Crit. Rev. Microbiol. 2020, 46, 450–462. [Google Scholar] [CrossRef]
- Spadaro, D.; Droby, S. Development of biocontrol products for postharvest diseases of fruit: The importance of elucidating the mechanisms of action of yeast antagonists. Trends Food Sci. Technol. 2016, 47, 39–49. [Google Scholar] [CrossRef]
- Li, Q.; Li, C.; Li, P.; Zhang, H.; Zhang, X.; Zheng, X.; Yang, Q.; Apaliya, M.T.; Boateng, N.A.S.; Sun, Y. The biocontrol effect of Sporidiobolus pararoseus Y16 against postharvest diseases in table grapes caused by Aspergillus niger and the possible mechanisms involved. Biol. Control 2017, 113, 18–25. [Google Scholar] [CrossRef]
- Mari, M.; Martini, C.; Spadoni, A.; Rouissi, W.; Bertolini, P. Biocontrol of apple postharvest decay by Aureobasidium pullulans. Postharvest Biol. Technol. 2012, 73, 56–62. [Google Scholar] [CrossRef]
- Zhang, X.; Wu, F.; Gu, N.; Yan, X.; Wang, K.; Dhanasekaran, S.; Gu, X.; Zhao, L.; Zhang, H. Postharvest biological control of Rhizopus rot and the mechanisms involved in induced disease resistance of peaches by Pichia membranefaciens. Postharvest Biol. Technol. 2020, 163, 111146. [Google Scholar] [CrossRef]
- Zhao, L.; Lan, C.; Tang, X.; Li, B.; Zhang, X.; Gu, X.; Zhang, H. Efficacy of Debaryomyce hansenii in the biocontrol for postharvest soft rot of strawberry and investigation of the physiological mechanisms involved. Biol. Control 2022, 174, 105011. [Google Scholar] [CrossRef]
- Wilson, C.L.; Wisniewski, M.E. Biological Control of Postharvest Diseases of Fruits and Vegetables: An Emerging Technology. Annu. Rev. Phytopathol. 1989, 27, 425–441. [Google Scholar] [CrossRef]
- Chanchaichaovivat, A.; Panijpan, B.; Ruenwongsa, P. Putative modes of action of Pichia guilliermondii strain R13 in controlling chilli anthracnose after harvest. Biol. Control 2008, 47, 207–215. [Google Scholar] [CrossRef]
- Tian, Y.-Q.; Li, W.; Jiang, Z.-T.; Jing, M.-M.; Shao, Y.-Z. The preservation effect of Metschnikowia pulcherrima yeast on anthracnose of postharvest mango fruits and the possible mechanism. Food Sci. Biotechnol. 2018, 27, 95–105. [Google Scholar] [CrossRef]
- Chan, Z.; Tian, S. Induction of H2O2-metabolizing enzymes and total protein synthesis by antagonistic yeast and salicylic acid in harvested sweet cherry fruit. Postharvest Biol. Technol. 2006, 39, 314–320. [Google Scholar] [CrossRef]
- Zhou, Y.; Li, W.; Zeng, J.; Shao, Y. Mechanisms of action of the yeast Debaryomyces nepalensis for control of the pathogen Colletotrichum gloeosporioides in mango fruit. Biol. Control 2018, 123, 111–119. [Google Scholar] [CrossRef]
- Madbouly, A.K.; Elyousr, K.A.A.; Ismail, I.M. Biocontrol of Monilinia fructigena, causal agent of brown rot of apple fruit, by using endophytic yeasts. Biol. Control 2020, 144, 104239. [Google Scholar] [CrossRef]
- Yang, H.; Wang, L.; Li, S.; Gao, X.; Wu, N.; Zhao, Y.; Sun, W. Control of postharvest grey spot rot of loquat fruit with Metschnikowia pulcherrima E1 and potential mechanisms of action. Biol. Control 2021, 152, 104406. [Google Scholar] [CrossRef]
- Parafati, L.; Restuccia, C.; Cirvilleri, G. Efficacy and mechanism of action of food isolated yeasts in the control of Aspergillus flavus growth on pistachio nuts. Food Microbiol. 2022, 108, 104100. [Google Scholar] [CrossRef] [PubMed]
- Liu, Y.; Yao, S.; Deng, L.; Ming, J.; Zeng, K. Different mechanisms of action of isolated epiphytic yeasts against Penicillium digitatum and Penicillium italicum on citrus fruit. Postharvest Biol. Technol. 2019, 152, 100–110. [Google Scholar] [CrossRef]
- Di Francesco, A.; Mari, M.; Ugolini, L.; Baraldi, E. Effect of Aureobasidium pullulans strains against Botrytis cinerea on kiwifruit during storage and on fruit nutritional composition. Food Microbiol. 2018, 72, 67–72. [Google Scholar] [CrossRef]
- Gao, Z.; Zhang, R.; Xiong, B. Management of postharvest diseases of kiwifruit with a combination of the biocontrol yeast Candida oleophila and an oligogalacturonide. Biol. Control 2021, 156, 104549. [Google Scholar] [CrossRef]
- Alimadadi, N.; Pourvali, Z.; Nasr, S.; Fazeli, S.A.S. Screening of antagonistic yeast strains for postharvest control of Penicillium expansum causing blue mold decay in table grape. Fungal Biol. 2023, 127, 901–908. [Google Scholar] [CrossRef]
- Zhu, Y.; Zong, Y.; Gong, D.; Zhang, X.; Oyom, W.; Yu, L.; Wang, X.; Bi, Y.; Prusky, D. Effects and possible modes of action of Kloeckera apiculata for controlling Penicillium expansum in apples. Biol. Control 2022, 169, 104898. [Google Scholar] [CrossRef]
- Ruiz-Moyano, S.; Martín, A.; Villalobos, M.; Calle, A.; Serradilla, M.; Córdoba, M.; Hernández, A. Yeasts isolated from figs (Ficus carica L.) as biocontrol agents of postharvest fruit diseases. Food Microbiol. 2016, 57, 45–53. [Google Scholar] [CrossRef]
- Shen, H.; Wei, Y.; Wang, X.; Xu, C.; Shao, X. The marine yeast Sporidiobolus pararoseus ZMY-1 has antagonistic properties against Botrytis cinerea in vitro and in strawberry fruit. Postharvest Biol. Technol. 2019, 150, 1–8. [Google Scholar] [CrossRef]
- Grzegorczyk, M.; Żarowska, B.; Restuccia, C.; Cirvilleri, G. Postharvest biocontrol ability of killer yeasts against Monilinia fructigena and Monilinia fructicola on stone fruit. Food Microbiol. 2017, 61, 93–101. [Google Scholar] [CrossRef]
- Zhang, X.; Li, B.; Zhang, Z.; Chen, Y.; Tian, S. Antagonistic Yeasts: A Promising Alternative to Chemical Fungicides for Controlling Postharvest Decay of Fruit. J. Fungi 2020, 6, 158. [Google Scholar] [CrossRef] [PubMed]
- Vargas, M.; Garrido, F.; Zapata, N.; Tapia, M. Isolation and Selection of Epiphytic Yeat for Biocontrol of Botrytis cinerea Pers. on Table Grapes. Chil. J. Agric. Res. 2012, 72, 332–337. [Google Scholar] [CrossRef]
- Rabosto, X.; Carrau, M.; Paz, A.; Boido, E.; Dellacassa, E.; Carrau, F.M. Grapes and Vineyard Soils as Sources of Microorganisms for Biological Control of Botrytis cinerea. Am. J. Enol. Vitic. 2006, 57, 332–338. [Google Scholar] [CrossRef]
- Swadling, I.R.; Jeffries, P. Isolation of Microbial Antagonists for Biocontrol of Grey Mould Disease of Strawberries. Biocontrol Sci. Technol. 1996, 6, 125–136. [Google Scholar] [CrossRef]
- Vero, S.; Mondino, P.; Burgueño, J.; Soubes, M.; Wisniewski, M. Characterization of biocontrol activity of two yeast strains from Uruguay against blue mold of apple. Postharvest Biol. Technol. 2002, 26, 91–98. [Google Scholar] [CrossRef]
- Esteve-Zarzoso, B.; Belloch, C.; Uruburu, F.; Querol, A. Identification of yeasts by RFLP analysis of the 5.8S rRNA gene and the two ribosomal internal transcribed spacers. Int. J. Syst. Evol. Microbiol. 1999, 49, 329–337. [Google Scholar] [CrossRef]
- Tamura, K.; Peterson, D.; Peterson, N.; Stecher, G.; Nei, M.; Kumar, S. MEGA5: Molecular Evolutionary Genetics Analysis Using Maximum Likelihood, Evolutionary Distance, and Maximum Parsimony Methods. Mol. Biol. Evol. 2011, 28, 2731–2739. [Google Scholar] [CrossRef]
- Jukes, T.H.; Cantor, C.R. Evolution of Protein Molecules. In Mammalian Protein Metabolism; Elsevier: Amsterdam, The Netherlands, 1969; pp. 21–132. ISBN 978-1-4832-3211-9. [Google Scholar]
- Saitou, N.; Nei, M. The neighbor-joining method: A new method for reconstructing phylogenetic trees. Mol. Biol. Evol. 1987, 4, 406–425. [Google Scholar] [CrossRef]
- Felsenstein, J. Phylogenies and the Comparative Method. Am. Nat. 1985, 125, 1–15. [Google Scholar] [CrossRef]
- Lutz, M.C.; Lopes, C.A.; Rodriguez, M.E.; Sosa, M.C.; Sangorrín, M.P. Efficacy and putative mode of action of native and commercial antagonistic yeasts against postharvest pathogens of pear. Int. J. Food Microbiol. 2013, 164, 166–172. [Google Scholar] [CrossRef]
- Bouzerda, L.; Boubaker, H.; Boudyach, E.H.; Akhayat, O.; Ait Ben Aoumar, A. Selection of Antagonistic Yeasts to Greend Mold Disease of Citrus in Morocco. J. Food Agric. Environ. 2003, 1, 215–218. [Google Scholar]
- Liu, J.; Wisniewski, M.; Droby, S.; Vero, S.; Tian, S.; Hershkovitz, V. Glycine betaine improves oxidative stress tolerance and biocontrol efficacy of the antagonistic yeast Cystofilobasidium infirmominiatum. Int. J. Food Microbiol. 2011, 146, 76–83. [Google Scholar] [CrossRef]
- Hernández-Montiel, L.G.; Larralde-Corona, C.P.; Vero, S.; López-Aburto, M.G.; Ochoa, J.L.; Ascencio-Valle, F. Caracterización de levaduras Debaryomyces hansenii para el control biológico de la podredumbre azul del limón mexicano Characterization of yeast Debaryomyces hansenii for the biological control of blue mold decay of Mexican lemon. CyTA-J. Food 2010, 8, 49–56. [Google Scholar] [CrossRef]
- Saligkarias, I.; Gravanis, F.; Epton, H. Biological control of Botrytis cinerea on tomato plants by the use of epiphytic yeasts Candida guilliermondii strains 101 and US 7 and Candida oleophila strain I-182: I. in vivo studies. Biol. Control 2002, 25, 143–150. [Google Scholar] [CrossRef]
- Bradford, M.M. A rapid and sensitive method for the quantitation of microgram quantities of protein utilizing the principle of protein-dye binding. Anal. Biochem. 1976, 72, 248–254. [Google Scholar] [CrossRef]
- Shin, S.H.; Lim, Y.; Lee, S.E.; Yang, N.W.; Rhee, J.H. CAS agar diffusion assay for the measurement of siderophores in biological fluids. J. Microbiol. Methods 2001, 44, 89–95. [Google Scholar] [CrossRef]
- Růžička, F.; Holá, V.; Votava, M.; Tejkalová, R. Importance of biofilm in Candida parapsilosis and evaluation of its susceptibility to antifungal agents by colorimetric method. Folia Microbiol. 2007, 52, 209–214. [Google Scholar] [CrossRef]
- Sabate, J.; Cano, J.; Esteve-Zarzoso, B.; Guillamon, J. Isolation and identification of yeasts associated with vineyard and winery by RFLP analysis of ribosomal genes and mitochondrial DNA. Microbiol. Res. 2002, 157, 267–274. [Google Scholar] [CrossRef]
- Lima, G.; Sanzani, S.; De Curtis, F.; Ippolito, A. Biological Control of Postharvest Diseases. In Advances in Postharvest Fruit and Vegetable Technology; Wills, R., Golding, J., Eds.; Contemporary Food Engineering; CRC Press: Boca Raton, FL, USA, 2015; pp. 65–88. ISBN 978-1-4822-1696-7. [Google Scholar]
- Parafati, L.; Vitale, A.; Restuccia, C.; Cirvilleri, G. Biocontrol ability and action mechanism of food-isolated yeast strains against Botrytis cinerea causing post-harvest bunch rot of table grape. Food Microbiol. 2015, 47, 85–92. [Google Scholar] [CrossRef]
- Nally, M.C.; Pesce, V.M.; Maturano, Y.P.; Muñoz, C.J.; Combina, M.; Toro, M.E.; de Figueroa, L.C.; Vazquez, F. Biocontrol of Botrytis cinerea in table grapes by non-pathogenic indigenous Saccharomyces cerevisiae yeasts isolated from viticultural environments in Argentina. Postharvest Biol. Technol. 2012, 64, 40–48. [Google Scholar] [CrossRef]
- Robiglio, A.; Sosa, M.C.; Lutz, M.C.; Lopes, C.A.; Sangorrín, M.P. Yeast Biocontrol of Fungal Spoilage of Pears Stored at Low Temperature. Int. J. Food Microbiol. 2011, 147, 211–216. [Google Scholar] [CrossRef] [PubMed]
- Zhang, D.; Spadaro, D.; Garibaldi, A.; Gullino, M.L. Potential biocontrol activity of a strain of Pichia guilliermondii against grey mold of apples and its possible modes of action. Biol. Control 2011, 57, 193–201. [Google Scholar] [CrossRef]
- Zhang, D.; Spadaro, D.; Garibaldi, A.; Gullino, M.L. Efficacy of the antagonist Aureobasidium pullulans PL5 against postharvest pathogens of peach, apple and plum and its modes of action. Biol. Control 2010, 54, 172–180. [Google Scholar] [CrossRef]
- Janisiewicz, W.J.; Tworkoski, T.J.; Sharer, C. Characterizing the Mechanism of Biological Control of Postharvest Diseases on Fruits with a Simple Method to Study Competition for Nutrients. Phytopathology 2000, 90, 1196–1200. [Google Scholar] [CrossRef] [PubMed]
- Di Francesco, A.; Ugolini, L.; D’Aquino, S.; Pagnotta, E.; Mari, M. Biocontrol of Monilinia laxa by Aureobasidium pullulans strains: Insights on competition for nutrients and space. Int. J. Food Microbiol. 2017, 248, 32–38. [Google Scholar] [CrossRef]
- Lima, G.; Ippolito, A.; Nigro, F.; Salerno, M. Effectiveness of Aureobasidium pullulans and Candida oleophila against postharvest strawberry rots. Postharvest Biol. Technol. 1997, 10, 169–178. [Google Scholar] [CrossRef]
- Ippolito, A.; El Ghaouth, A.; Wilson, C.L.; Wisniewski, M. Control of postharvest decay of apple fruit by Aureobasidium pullulans and induction of defense responses. Postharvest Biol. Technol. 2000, 19, 265–272. [Google Scholar] [CrossRef]
- Schena, L.; Nigro, F.; Pentimone, I.; Ligorio, A.; Ippolito, A. Control of postharvest rots of sweet cherries and table grapes with endophytic isolates of Aureobasidium pullulans. Postharvest Biol. Technol. 2003, 30, 209–220. [Google Scholar] [CrossRef]
- Vero, S.; Garmendia, G.; González, M.B.; Garat, M.F.; Wisniewski, M. Aureobasidium pullulans as a biocontrol agent of postharvest pathogens of apples in Uruguay. Biocontrol Sci. Technol. 2009, 19, 1033–1049. [Google Scholar] [CrossRef]
- Wang, X.; Glawe, D.A.; Kramer, E.; Weller, D.; Okubara, P.A. Biological Control of Botrytis cinerea: Interactions with Native Vineyard Yeasts from Washington State. Phytopathology 2018, 108, 691–701. [Google Scholar] [CrossRef]
- Sun, C.; Huang, Y.; Lian, S.; Saleem, M.; Li, B.; Wang, C. Improving the biocontrol efficacy of Meyerozyma guilliermondii Y-1 with melatonin against postharvest gray mold in apple fruit. Postharvest Biol. Technol. 2021, 171, 111351. [Google Scholar] [CrossRef]
- Agarbati, A.; Canonico, L.; Pecci, T.; Romanazzi, G.; Ciani, M.; Comitini, F. Biocontrol of Non-Saccharomyces Yeasts in Vineyard against the Gray Mold Disease Agent Botrytis cinerea. Microorganisms 2022, 10, 200. [Google Scholar] [CrossRef] [PubMed]
- Spadaro, D.; Vola, R.; Piano, S.; Gullino, M.L. Mechanisms of action and efficacy of four isolates of the yeast Metschnikowia pulcherrima active against postharvest pathogens on apples. Postharvest Biol. Technol. 2002, 24, 123–134. [Google Scholar] [CrossRef]
- Long, C.-A.; Wu, Z.; Deng, B.-X. Biological control of Penicillium italicum of Citrus and Botrytis cinerea of Grape by Strain 34–9 of Kloeckera apiculata. Eur. Food Res. Technol. 2005, 221, 197–201. [Google Scholar] [CrossRef]
- Zhang, H.; Wang, L.; Dong, Y.; Jiang, S.; Cao, J.; Meng, R. Postharvest biological control of gray mold decay of strawberry with Rhodotorula glutinis. Biol. Control 2007, 40, 287–292. [Google Scholar] [CrossRef]
- Liu, H.M.; Guo, J.H.; Cheng, Y.J.; Luo, L.; Liu, P.; Wang, B.Q.; Deng, B.X.; Long, C.A. Control of gray mold of grape by Hanseniaspora uvarum and its effects on postharvest quality parameters. Ann. Microbiol. 2010, 60, 31–35. [Google Scholar] [CrossRef]
- Manso, T.; Nunes, C. Metschnikowia andauensis as a new biocontrol agent of fruit postharvest diseases. Postharvest Biol. Technol. 2011, 61, 64–71. [Google Scholar] [CrossRef]
- Li, W.; Zhang, H.; Li, P.; Apaliya, M.T.; Yang, Q.; Peng, Y.; Zhang, X. Biocontrol of postharvest green mold of oranges by Hanseniaspora uvarum Y3 in combination with phosphatidylcholine. Biol. Control 2016, 103, 30–38. [Google Scholar] [CrossRef]
- Hu, H.; Wisniewski, M.E.; Abdelfattah, A.; Zheng, X. Biocontrol activity of a cold-adapted yeast from Tibet against gray mold in cherry tomato and its action mechanism. Extremophiles 2017, 21, 789–803. [Google Scholar] [CrossRef]
- Hernandez-Montiel, L.G.; Gutierrez-Perez, E.D.; Murillo-Amador, B.; Vero, S.; Chiquito-Contreras, R.G.; Rincon-Enriquez, G. Mechanisms employed by Debaryomyces hansenii in biological control of anthracnose disease on papaya fruit. Postharvest Biol. Technol. 2018, 139, 31–37. [Google Scholar] [CrossRef]
- Wang, K.; Cao, S.; Rui, H.; Zheng, Y.; Jin, P. Biological Control of Green Mould Decay in Postharvest Chinese Bayberries by Pichia membranaefaciens. J. Phytopathol. 2011, 159, 417–423. [Google Scholar] [CrossRef]
- Lahlali, R.; Hamadi, Y.; El Guilli, M.; Jijakli, M.H. Efficacy assessment of Pichia guilliermondii strain Z1, a new biocontrol agent, against citrus blue mould in Morocco under the influence of temperature and relative humidity. Biol. Control 2011, 56, 217–224. [Google Scholar] [CrossRef]
- Tang, J.; Liu, Y.; Li, H.; Wang, L.; Huang, K.; Chen, Z. Combining an antagonistic yeast with harpin treatment to control postharvest decay of kiwifruit. Biol. Control 2015, 89, 61–67. [Google Scholar] [CrossRef]
- Sui, Y.; Wang, Z.; Zhang, D.; Wang, Q. Oxidative stress adaptation of the antagonistic yeast, Debaryomyces hansenii, increases fitness in the microenvironment of kiwifruit wound and biocontrol efficacy against postharvest diseases. Biol. Control 2021, 152, 104428. [Google Scholar] [CrossRef]
- Liu, J.; Sui, Y.; Wisniewski, M.; Droby, S.; Liu, Y. Utilization of antagonistic yeasts to manage postharvest fungal diseases of fruit. Int. J. Food Microbiol. 2013, 167, 153–160. [Google Scholar] [CrossRef]
- Di Francesco, A.; Martini, C.; Mari, M. Biological control of postharvest diseases by microbial antagonists: How many mechanisms of action? Eur. J. Plant Pathol. 2016, 145, 711–717. [Google Scholar] [CrossRef]
- Yu, T.; Zhang, H.; Li, X.; Zheng, X. Biocontrol of Botrytis cinerea in apple fruit by Cryptococcus laurentii and indole-3-acetic acid. Biol. Control 2008, 46, 171–177. [Google Scholar] [CrossRef]
- Torres, R.; Teixidó, N.; Usall, J.; Abadias, M.; Mir, N.; Larrigaudiere, C.; Viñas, I. Anti-oxidant activity of oranges after infection with the pathogen Penicillium digitatum or treatment with the biocontrol agent Pantoea agglomerans CPA-2. Biol. Control 2011, 57, 103–109. [Google Scholar] [CrossRef]
- Santos, A.; Sánchez, A.; Marquina, D. Yeasts as biological agents to control Botrytis cinerea. Microbiol. Res. 2004, 159, 331–338. [Google Scholar] [CrossRef]
- Bar-Shimon, M.; Yehuda, H.; Cohen, L.; Weiss, B.; Kobeshnikov, A.; Daus, A.; Goldway, M.; Wisniewski, M.; Droby, S. Characterization of extracellular lytic enzymes produced by the yeast biocontrol agent Candida oleophila. Curr. Genet. 2004, 45, 140–148. [Google Scholar] [CrossRef]
- Delali, K.I.; Chen, O.; Wang, W.; Yi, L.; Deng, L.; Zeng, K. Evaluation of yeast isolates from kimchi with antagonistic activity against green mold in citrus and elucidating the action mechanisms of three yeast: P. kudriavzevii, K. marxianus, and Y. lipolytica. Postharvest Biol. Technol. 2021, 176, 111495. [Google Scholar] [CrossRef]
- Wang, W.; Chi, Z.; Li, J.; Wang, X. Siderophore production by the marine-derived Aureobasidium pullulans and its antimicrobial activity. Bioresour. Technol. 2009, 100, 2639–2641. [Google Scholar] [CrossRef]
- Saravanakumar, D.; Ciavorella, A.; Spadaro, D.; Garibaldi, A.; Gullino, M.L. Metschnikowia pulcherrima strain MACH1 outcompetes Botrytis cinerea, Alternaria alternata and Penicillium expansum in apples through iron depletion. Postharvest Biol. Technol. 2008, 49, 121–128. [Google Scholar] [CrossRef]
- Nally, M.; Pesce, V.; Maturano, Y.; Assaf, L.R.; Toro, M.; de Figueroa, L.C.; Vazquez, F. Antifungal modes of action of Saccharomyces and other biocontrol yeasts against fungi isolated from sour and grey rots. Int. J. Food Microbiol. 2015, 204, 91–100. [Google Scholar] [CrossRef] [PubMed]
- Sansone, G.; Rezza, I.; Calvente, V.; Benuzzi, D.; de Tosetti, M.I.S. Control of Botrytis cinerea strains resistant to iprodione in apple with rhodotorulic acid and yeasts. Postharvest Biol. Technol. 2005, 35, 245–251. [Google Scholar] [CrossRef]
- Verstrepen, K.J.; Klis, F.M. Flocculation, adhesion and biofilm formation in yeasts. Mol. Microbiol. 2006, 60, 5–15. [Google Scholar] [CrossRef]
and apples
against Botrytis cinerea in dual culture on MEA plates at 25 °C. The inhibition of mycelium growth was evaluated in accordance with the scale: 0 = no visible signs of Botrytis cinerea inhibition and mycelium surpassed the yeast colony; 1 = both organisms stopped growing on contact; 2 = inhibition zone between pathogen and antagonist was <2 mm; 3 = inhibition zone was between 2 and 4 mm; 4 = inhibition zone was >4 mm.
and apples
against Botrytis cinerea in dual culture on MEA plates at 25 °C. The inhibition of mycelium growth was evaluated in accordance with the scale: 0 = no visible signs of Botrytis cinerea inhibition and mycelium surpassed the yeast colony; 1 = both organisms stopped growing on contact; 2 = inhibition zone between pathogen and antagonist was <2 mm; 3 = inhibition zone was between 2 and 4 mm; 4 = inhibition zone was >4 mm.

| Yeast Strains | PCR Product ITS1-ITS4 | Restriction Fragments | Species | ||
|---|---|---|---|---|---|
| HaeIII | HinfI | HhaI | |||
| m11 | 600 | 400 + 115 + 90 | 320 + 300 | 300 + 265 + 60 | Meyerozyma guilliermondii 1 |
| me99 | 590 | 460 + 150 | 290 + 180 + 130 | 190 + 180 + 100 | Aureobasidium pullulans 2 |
| ca80 | 590 | 460 + 150 | 290 + 180 + 130 | 190 + 180 + 100 | Aureobasidium pullulans 2 |
| Concentration of Yeast (Cells mL−1) | Conidial Germination Index (%) * | ||
|---|---|---|---|
| m11 | me99 | ca80 | |
| Control | 100.00 ± 0.00 a | 100.00 ± 0.00 a | 100.00 ± 0.00 a |
| 1 × 105 | 99.67 ± 0.33 a | 100.00 ± 0.00 a | 97.67 ± 0.67 a |
| 1 × 106 | 92.67± 3.28 a | 90.00 ± 2.65 b | 96.33 ± 0.67 a |
| 1 × 107 | 18.00± 3.00 b | 23.33 ± 3.48 c | 19.67 ± 2.33 b |
| 1 × 108 | 3.67 ± 1.33 c | 6.67 ± 0.88 d | 0.33 ± 0.33 c |
| 1 × 109 | 0.00 ± 0.00 c | 0.00 ± 0.00 d | 0.00 ± 0.00 c |
| Concentration of Yeast (Cells mL−1) | Rot Incidence (%) | ||
|---|---|---|---|
| m11 | me99 | ca80 | |
| Control | 78.81 ± 4.76 c | 84.52 ± 6.63 b | 94.05 ± 1.19 c |
| 1 × 107 | 34.52 ± 7.81 b | 64.29 ± 5.46 b | 60.71 ± 7.14 b |
| 1 × 108 | 20.24 ± 4.76 ab | 35.71 ± 2.06 a | 33.33 ± 5.19 a |
| 1 × 109 | 11.90 ± 6.30 a | 26.19 ± 7.81 a | 32.14 ± 2.06 a |
| Yeast Strain | pH | |||
|---|---|---|---|---|
| 4.2 | 4.6 | 5.0 | 5.4 | |
| Control * | − | − | − | − |
| m11 | − | + | + | − |
| me99 | + | + | − | − |
| ca80 | + | + | + | − |
| Yeast Strain | Siderophore Production | Biofilm Formation | |
|---|---|---|---|
| Absorbance (A620) | |||
| m11 | − | 0.076 ± 0.006 | + |
| me99 | + | 0.008 ± 0.002 | − |
| ca80 | + | 0.010 ± 0.001 | − |
Disclaimer/Publisher’s Note: The statements, opinions and data contained in all publications are solely those of the individual author(s) and contributor(s) and not of MDPI and/or the editor(s). MDPI and/or the editor(s) disclaim responsibility for any injury to people or property resulting from any ideas, methods, instructions or products referred to in the content. |
© 2023 by the authors. Licensee MDPI, Basel, Switzerland. This article is an open access article distributed under the terms and conditions of the Creative Commons Attribution (CC BY) license (https://creativecommons.org/licenses/by/4.0/).
Share and Cite
Sepúlveda, X.; Vargas, M.; Vero, S.; Zapata, N. Indigenous Yeasts for the Biocontrol of Botrytis cinerea on Table Grapes in Chile. J. Fungi 2023, 9, 557. https://doi.org/10.3390/jof9050557
Sepúlveda X, Vargas M, Vero S, Zapata N. Indigenous Yeasts for the Biocontrol of Botrytis cinerea on Table Grapes in Chile. Journal of Fungi. 2023; 9(5):557. https://doi.org/10.3390/jof9050557
Chicago/Turabian StyleSepúlveda, Ximena, Marisol Vargas, Silvana Vero, and Nelson Zapata. 2023. "Indigenous Yeasts for the Biocontrol of Botrytis cinerea on Table Grapes in Chile" Journal of Fungi 9, no. 5: 557. https://doi.org/10.3390/jof9050557
APA StyleSepúlveda, X., Vargas, M., Vero, S., & Zapata, N. (2023). Indigenous Yeasts for the Biocontrol of Botrytis cinerea on Table Grapes in Chile. Journal of Fungi, 9(5), 557. https://doi.org/10.3390/jof9050557

